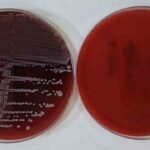

Fosseptik Çukuruna Düşen İki Kişiden Biri Hayatını Kaybetti
Sivas’ın Şarkışla ilçesinde bulunan Kayapınar köyünde feci bir olay meydana geldi. Kırsaldaki bir çiftlik evinin bahçesindeki fosseptik çukuruna düşen yabancı uyruklu iki kişiden biri hayatını kaybetti.
Olayın Ayrıntıları
Bugün saat 14.00 sıralarında gerçekleşen olayda, henüz belirlenemeyen bir nedenle çukura düşen iki kişi, çevredekiler tarafından fark edildi. İhbar üzerine bölgeye acil durum ekipleri olan AFAD ve sağlık ekipleri intikal etti. AFAD’ın gerçekleştirdiği operasyon sonucunda çukurdan kurtarılan kişilerin durumu kritik oldu. Yapılan incelemede, adının açıklanmadığı bir kişinin hayatını kaybettiği belirlendi. Diğer kişinin ise hastaneye sevk edildiği, durumunun ciddiyetini koruduğu ifade edildi. Olayla ilgili olarak başlatılan soruşturma devam ediyor.